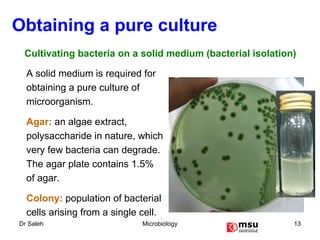
Obtaining a pure culture A solid medium is required for obtaining a pure culture of microorganism. Agar:   an algae extract, polysaccharide in nature, which very few bacteria can degrade. The agar plate contains 1.5% of agar. Colony:   population of bacterial cells arising from a single cell. Cultivating bacteria on a solid medium (bacterial isolation)
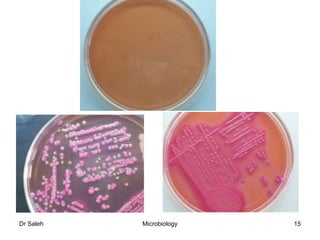

The document discusses bacterial physiology and growth. It covers the following key points:
1) Bacteria require nutrients like carbon, nitrogen, oxygen, hydrogen, sulfur, and phosphorus for growth. They also require growth factors and microelements.
2) Environmental factors that affect bacterial growth include temperature, pH, oxygen availability, and water availability.
3) Bacteria are commonly grown in the laboratory using solid or liquid culture media, which must be sterilized to obtain a pure culture and prevent contamination.
4) The bacterial growth curve consists of four phases: lag, log (exponential), stationary, and death phases. The bacteria acclimate, multiply rapidly, stop growing due to lack of nutrients,